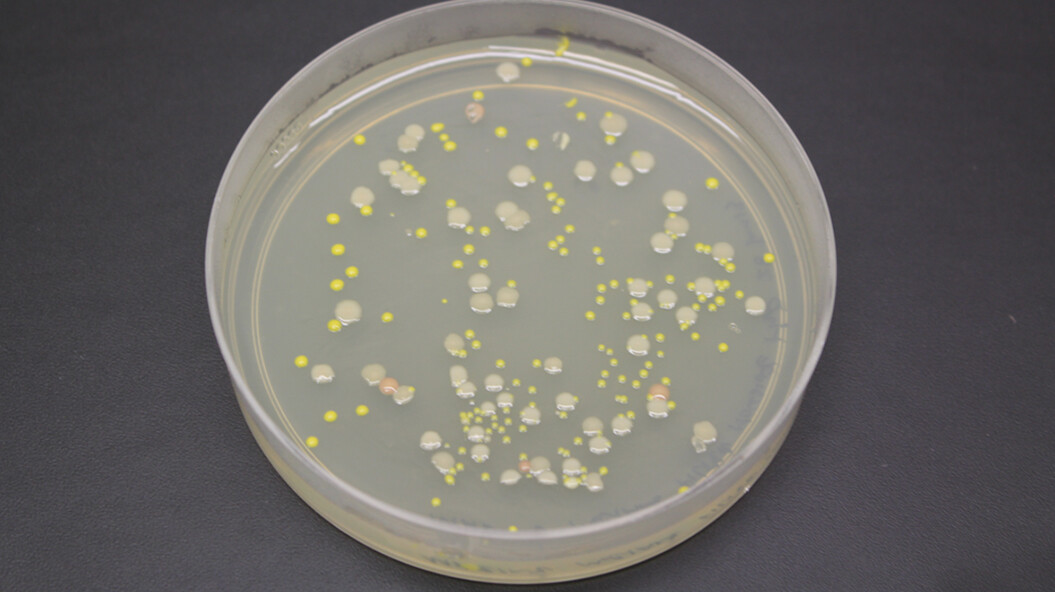

A study published Aug. 21 in the journal Nature unveils the first detailed description of microbial life forms discovered in a lake beneath the Antarctic ice sheet.
Samples of water and sediment containing the microorganisms were obtained after a team of engineers and technicians from UNL used a specially designed hot water drill to bore through 800 meters of ice covering Lake Whillans in West Antarctica in January 2013.
The UNL drilling team is part of the Whillans Ice Stream Subglacial Access Research Drilling, or WISSARD, project funded by the National Science Foundation. It is an interdisciplinary effort of scientists from around the world.
“The confirmation of microbial life existing in Subglacial Lake Whillans is a very exciting achievement,” said Frank Rack, executive director of the Antarctic Drilling (ANDRILL) Science Management Office at UNL. “The UNL Science Management Office and the UNL drill team are proud to have contributed to the exploration of this unique subglacial environment through the design, fabrication and operation of the hot water drill used to provide access to Subglacial Lake Whillans.”
Brent Christner, a Louisiana State University biologist and lead author of the Nature paper, said scientific analysis of the samples confirms that aquatic environments beneath the Antarctic ice sheet support viable microbial ecosystems.
“Hidden beneath a half-mile of ice in Antarctica is an unexplored part of our biosphere,” he said in a LSU press release. “WISSARD has provided a glimpse of the nature of microbial life that may lurk under more than five million square miles of ice sheet.”
Other co-authors of the paper hail from Montana State University, Bozeman, the University of Venice in Italy, the Scripps Instituteion of Oceanography, St. Olaf College in Minnesota; the University of Tennessee and Aberystwyth University in the United Kingdom.
Key to the success of the project was developing a drill that would not introduce foreign material into the lake. The team of engineers and technicians directed by Rack designed and fabricated the specialized hot-water drill fitted with a filtration and germicidal system to recover clean samples for analysis.
Other members of the UNL drilling team included Dennis Duling, Daren Blythe, Justin Burnett, Chad Carpenter, Dar Gibson, Jeff Lemery, Adam Melby and Graham Roberts.
UNL will continue to support the WISSARD Project’s science team in the next phase of their research, which is planned for December 2014 through January 2015, when the UNL drill team will use the WISSARD hot water drill system to provide access through about 800 meters of ice at the grounding zone of the West Antarctic Ice Sheet/Whillans Ice Stream, at a location about 60 miles north of Subglacial Lake Whillans.
At this location where the grounded ice sheet transitions into the floating Ross Ice Shelf, the new borehole will provide access through the ice to allow scientific instruments, sampling devices, and a remotely operated underwater vehicle known as Deep-SCINI, which has been developed by the UNL Science Management Office, to explore the ice shelf cavity in the ocean water just in front of the grounding zone for the first time.